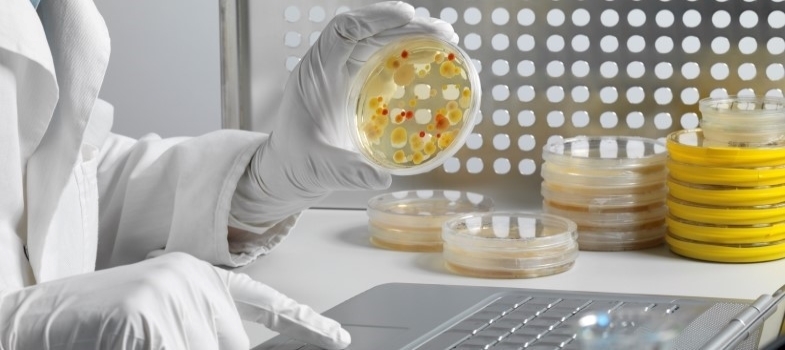
Sampling (animal health) (2025)

Antimicrobial resistance (AMR) is a major global concern because drug-resistant infections can kill, spread to others, and impose huge costs on individuals and society. In order to tackle this problem we first need to understand it; we can do this by collecting and sharing high-quality data that is relevant to AMR.
Data relating to AMR means that trends in resistance and antimicrobial use can be monitored and used to make better decisions to help tackle the AMR crisis. As an AMR surveillance professional, you have a key role to play in this surveillance process, whether it is in collecting, analysing or interpreting data, or in using the data to develop new policies and practices.
This Fleming Fund programme, Tackling antimicrobial resistance, comprises a series of online courses. The aim of this programme is to help you to identify, develop and apply skills and knowledge relevant to your role in order to change and improve your working practice and the practice of people that you work with.
Sampling (animal health) focuses on sampling for AMR surveillance in in livestock and aquatic animal health, drawing comparisons to human health where relevant, as part of the emphasis on the importance of One Health approaches in tackling AMR.